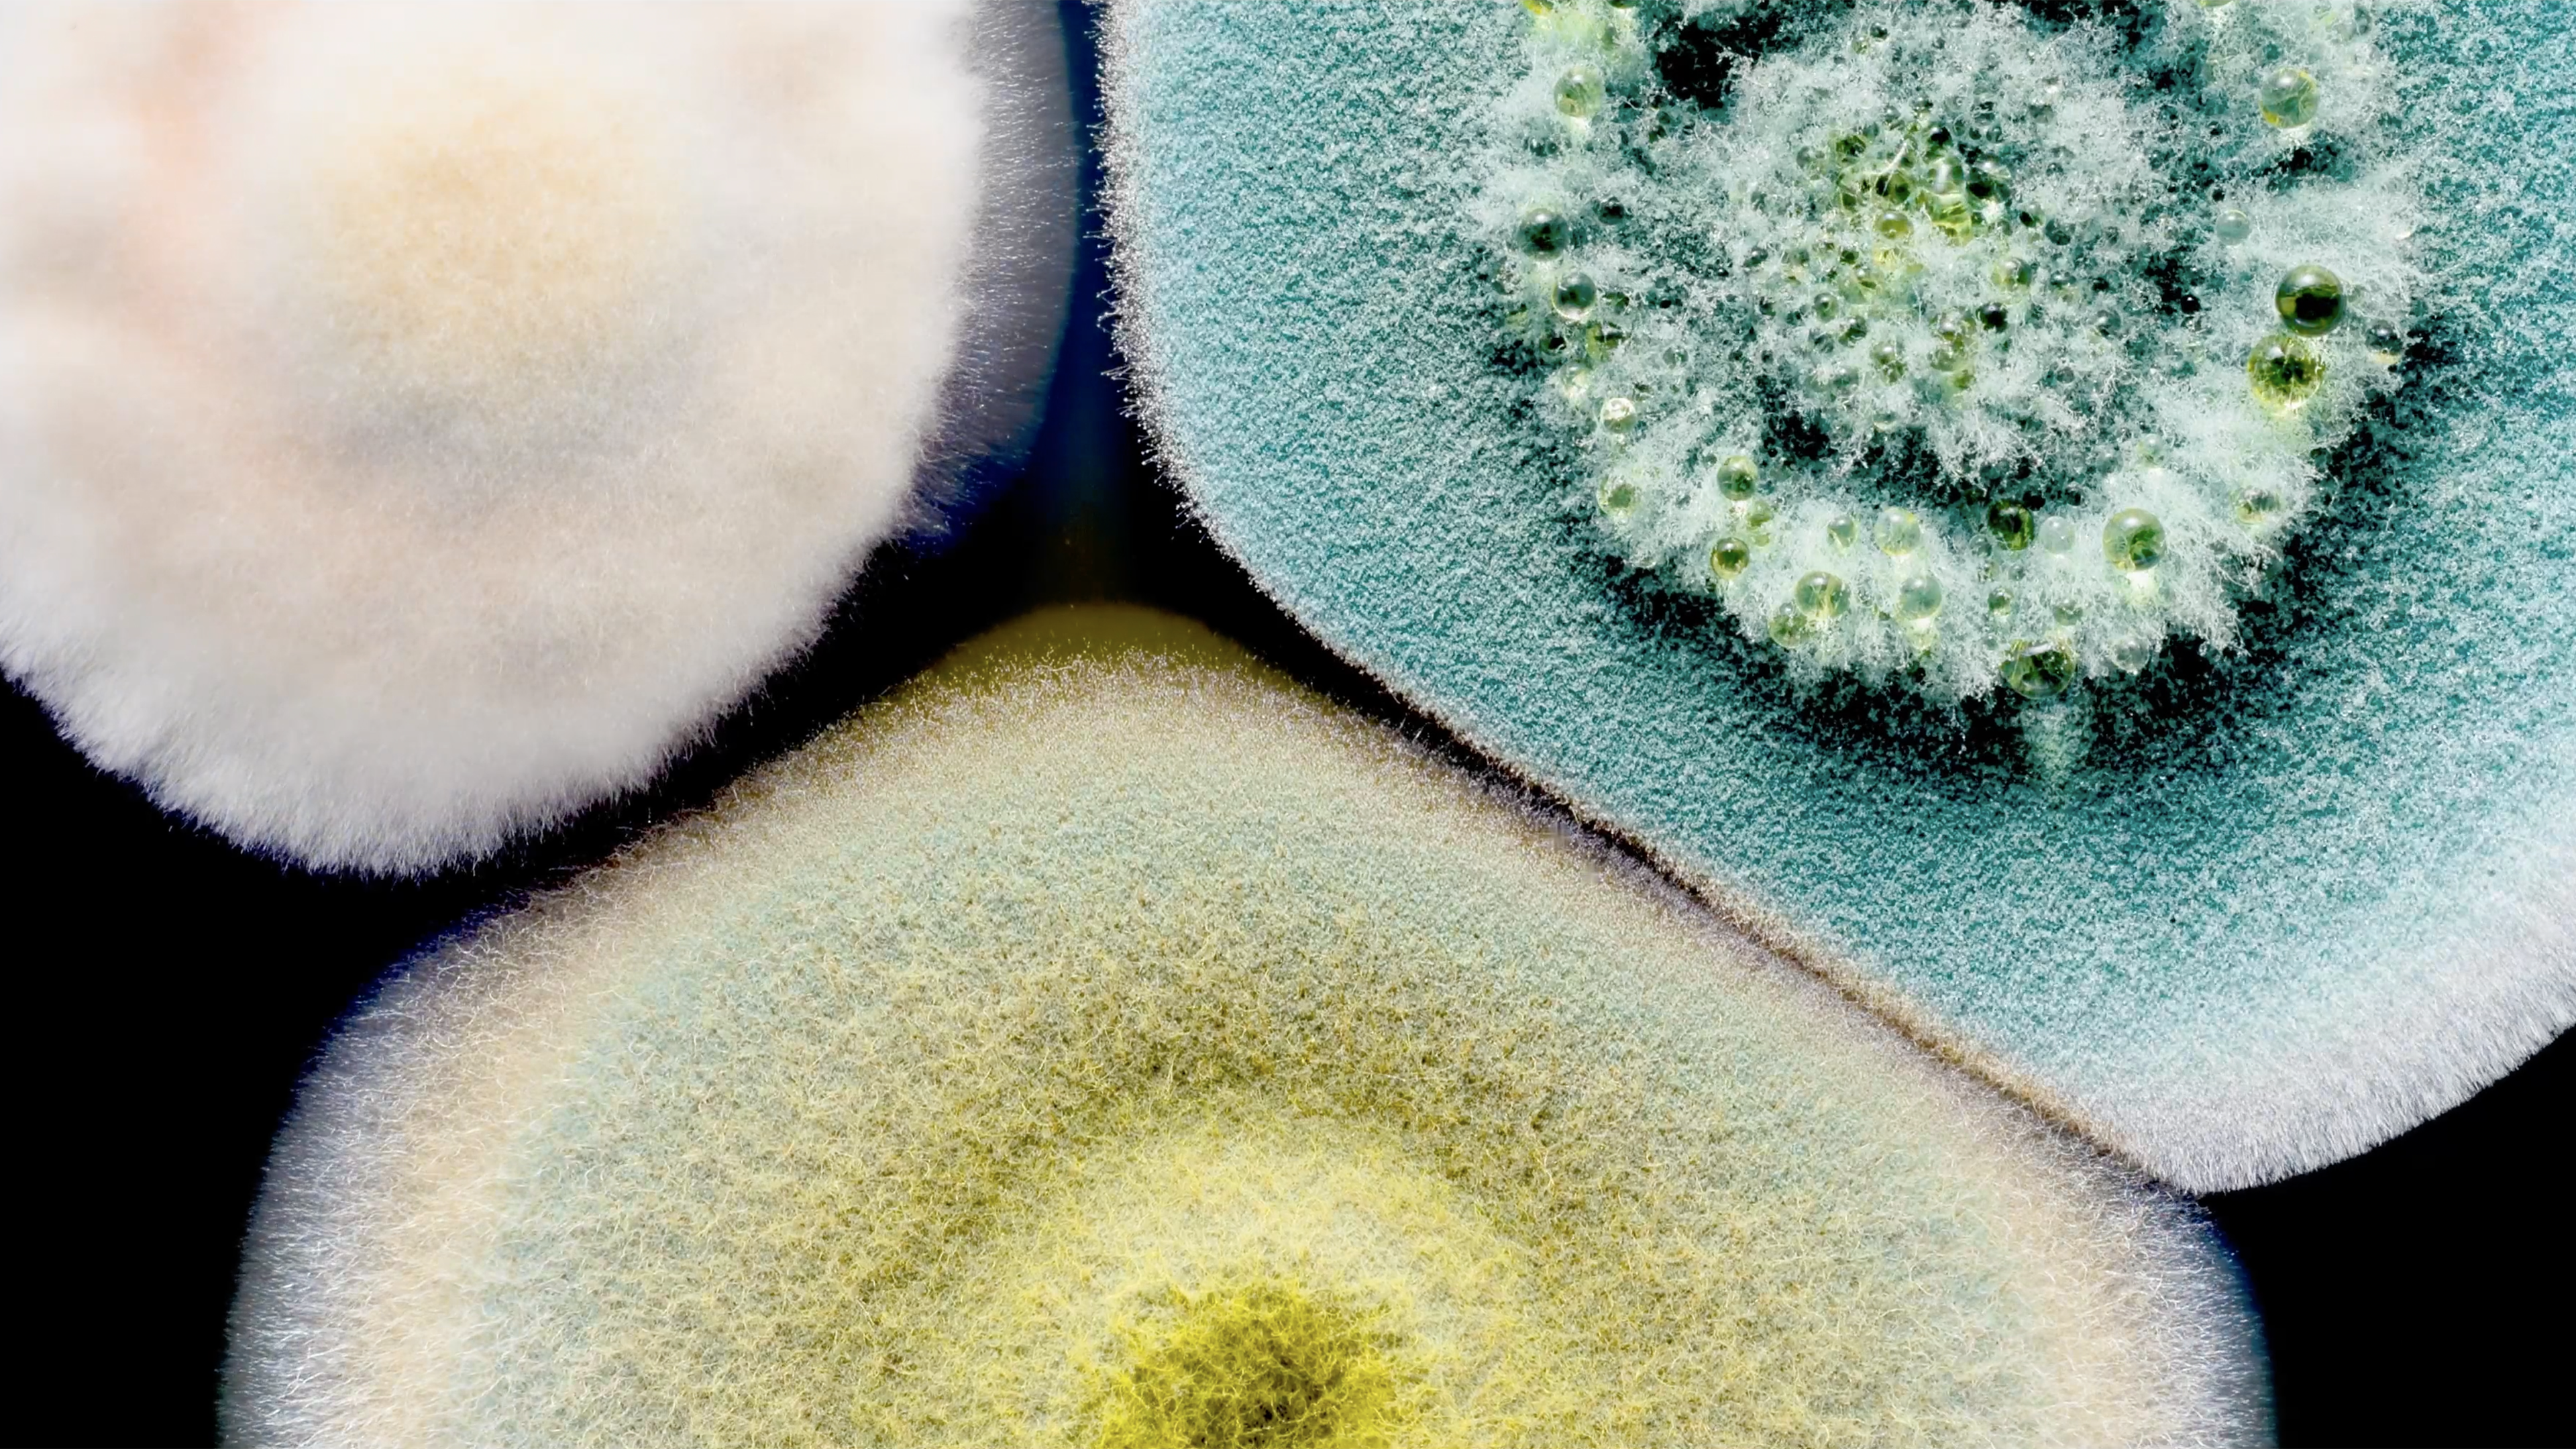

Fungi: The Web of Life
Through the eyes of passionate biologist and writer Merlin Sheldrake, join us on this brilliant round-the-world journey into the secret world of fungi. Through dazzling images of fungi under the microscope, and all around us in the forest, Merlin unravels the many secrets of these essential organisms in the web of life. So much more than mushrooms, not only do fungi shape the weather and support life on land, they are at the cutting edge of medical research and even have the power to break down plastic waste.
Narrator and iconic artist Björk, takes us from the ancient Tasmanian Tarkine Rainforest to the mystical wilds of China’s Yunnan Province, in search of solutions to some of our planet’s biggest challenges. Can the answers be found in the wonderful world of fungi?